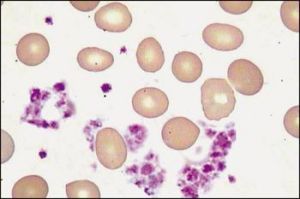
小兒巨大血小板綜合徵

病因
BSS為染色體異常性疾病,患者血小板膜糖蛋白GPIb/Ⅸ缺乏或功能異常。GPIb/Ⅸ複合物是血小板黏附必需物質,GPIb是血小板表面血管性血友病因子(vWF)受體,是血小板黏附的主要受體,血小板通過GPIb與vWF結合而黏附於皮下組織。由於本病患者GPIb/Ⅸ缺乏,導致血小板黏附功能異常,同時伴血小板減少。此外,患者血小板體積增大,直徑>4µm,大似淋巴細胞,電鏡下發現血小板膜系統明顯異常,細胞內空泡,表面連線系統、緻密管系統、微管系統及膜複合物增多。
臨床表現
雜合子可有血小板體積增大等生物學異常,但無出血症狀。純合子多有中到重度的出血,以皮膚黏膜自發性出血為主,如瘀點、瘀斑、鼻出血、牙齦出血、胃腸道出血、月經過多等。
檢查
血小板計數減少伴巨大血小板,出血時間延長、血小板黏附功能降低,瑞斯托黴素及人或牛的vWF不能誘導血小板聚集,低濃度的凝血酶誘導血小板聚集降低。如做膜糖蛋白測定,可發現血小板膜GPIb、Ⅸ及Ⅴ降低或缺乏。根據臨床需要選擇,常規做B超檢查。
診斷
國內1986年修改的巨大血小板綜合徵診斷標準如下:
1.臨床表現
(1)常染色體隱性遺傳,男女均可患病。
(2)輕度至中度皮膚、黏膜出血,女性月經過多。
(3)肝脾不大。
2.實驗室檢查
(1)血小板減少伴巨大血小板。
(2)出血時間延長。
(3)血小板聚集試驗加瑞斯托黴素,不聚集。加其他誘聚劑,聚集基本正常。
(4)vWF正常。
(5)血小板膜缺乏糖蛋白Ib(GpIb)。
(6)排除繼發性巨血小板症。
鑑別診斷
1.血小板無力症
常染色體隱性遺傳病,血小板有功能缺陷,血小板計數和形態均正常,血小板對腺苷二磷酸(ADP)等無聚集,血小板黏附功能正常,血小板GPⅡb/Ⅲa缺乏。
2.血小板貯存池病
血小板計數和形態正常,而血小板內緻密體減少或缺乏,對ADP等引起的聚集試驗第一相聚集正常,第二相聚集缺乏,本病尚需與其他遺傳性血小板功能缺陷性疾病及斷髮性血小板功能缺陷性疾病相鑑別。
治療
1.護理
在診斷明確的患兒,醫務人員應儘量向家長說明病情,告訴家長如何護理孩子,教育孩子自我保護,避免外傷,減少出血。
2.局部出血
出血不嚴重時,多可用吸收性明膠海綿、凝血酶等壓迫止血,青春期月經過多時可採用避孕藥如炔雌醇/炔諾酮以控制月經量。
3.1-脫氧-8-精氨酸加壓素(DDAVP)
本藥可提高血漿凝血因子Ⅷ活性、vW因子活性從而幫助止血,但有抗利尿副作用。
4.嚴重出血
嚴重出血者需輸注血小板濃縮製劑,反覆輸注易產生抗小板抗體而失效,因此有條件者宜做ABO及HLA配型,給予去白細胞的同型血小板製劑,不易引起同種免疫。對於已產生抗血小板抗體的患兒,可使用血漿交換以減少抗體後再輸同型血小板製劑,有時可靜脈給予人血丙種球蛋白亦有幫助。也可以套用重組凝血因子Ⅶ幫助止血。
5.骨髓移植或基因治療
嚴重的患兒如能找到合適的供體可進行異基因骨髓移植、臍血幹細胞移植,一旦成功即可根治。基因治療正在研究中,目前尚無成功的報導。